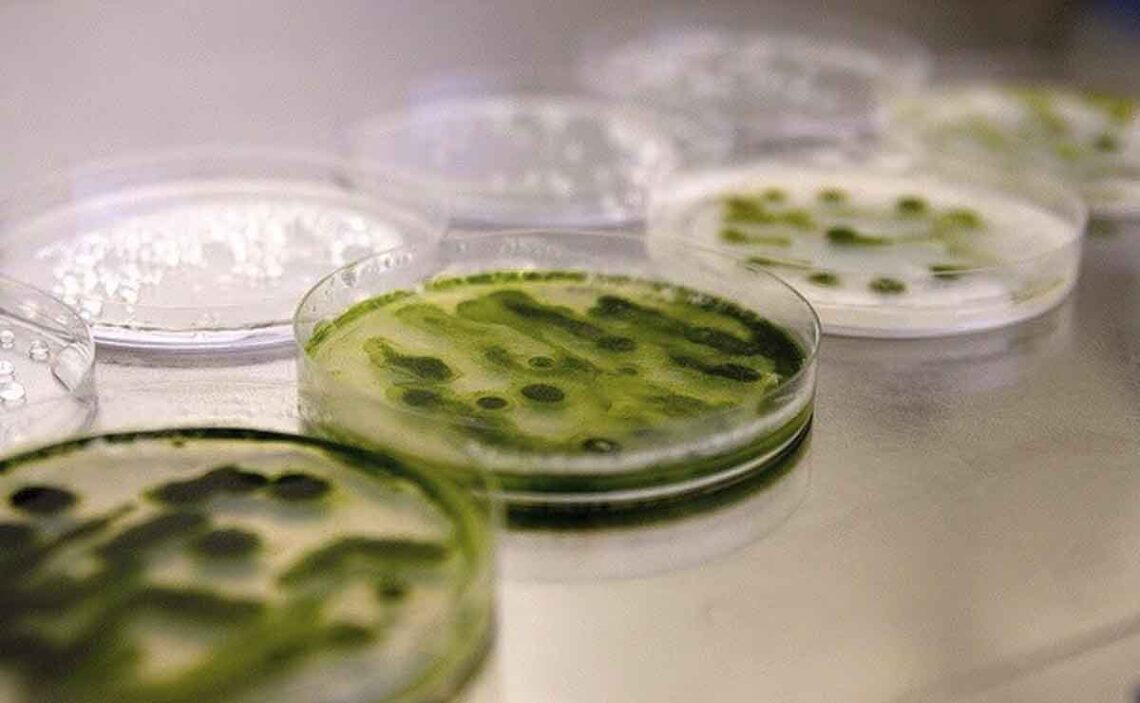

Investigadores de la Universidad de Huelva han descubierto que animales alimentados por un tipo de alga de Huelva fueron capaces de disminuir su riesgo cardiovascular. Los resultados han revelado su eficacia para el tratamiento de los triglicéridos, la hipertensión, obesidad, diabetes y algunas enfermedades de corazón.
Este equipo de la Onubense ha confirmado que la ingesta de Coccomyxa onubensis, una microalga aislada en Riotinto (Huelva); promueve la reducción del 39 por ciento de azúcar en sangre y casi un 26 por ciento del colesterol total. Esta cifra es similar a la obtenida con la medicación más usada para el tratamiento del colesterol y triglicéridos elevados, las estatinas.
Si bien, este microorganismo se ha convertido en un complemento perfecto para aquellos pacientes que no están logrando los resultados esperados solo con fármacos. El estudio ha demostrado los efectos reductores de triglicéridos, azúcar y colesterol en animales modelo de investigación enfermos con el síndrome metabólico; una dolencia que agrupa varios factores de riesgo de enfermedad cardiaca, como diabetes, obesidad, hipertensión, hipercolesterolemia y otros problemas de salud.
Tras este estudio, los expertos comenzarán la fase clínica que aplicará este microorganismo en enfermos a los que el tratamiento de estatinas no les funciona. Según recoge el artículo ‘The acidophilic microalga Coccomyxa onubensis and atorvastatin equally improve antihyperglycemic and antihyperlipidemic protective effects on rats fed on high-fat diets’, publicado en la revista Journal of Applied Phycology, la acción de la microalga reduce en roedores las patologías que causan enfermedades cardiovasculares.
Los resultados abren la puerta a pruebas reales en pacientes
En otros estudios, los expertos analizaron la composición de Coccomyxa onubensis concluyendo que es un alga rica en proteínas y fibra, además de una fuente de alto valor nutricional por su contenido en omega 3, concretamente en DHA, que contribuye al desarrollo cognitivo y refuerza el sistema inmunitario.

De hecho, cuenta con pocos azúcares y ácidos grasos. «Una vez que determinamos que no implica ningún perjuicio ni efecto tóxico, hemos incluido la microalga en la dieta de animales de laboratorio comprobando que, efectivamente, contribuye a la reducción de azúcar, colesterol y triglicéridos plasmáticos, mejorando sustancialmente su salud»; ha indicado a la Fundación Descubre el investigador de la Universidad de Huelva Francisco Navarro, autor del artículo.
De esta manera, este trabajo abre la puerta a las pruebas reales con pacientes que tienen dificultad para bajar sus niveles de glucosa o colesterol y que no responden correctamente a los tratamientos con estatina. Esto se debe, principalmente, a la genética del paciente; ya que hay enfermos que por un defecto en el cromosoma 19 no consiguen eliminar el colesterol malo (LDL) de la sangre. A esta dolencia se la denomina hipercolesterolemia familiar.
Según indica el investigador, el mecanismo de acción de la estatina y de la microalga es distinto. Es decir, cada uno sigue una vía metabólica diferente en el organismo debido a las enzimas que interactúan con ellas durante su descomposición. «Así, los pacientes con esta incompatibilidad podrían tener un complemento válido para reducir sus problemas de salud», afirma.
Reducción del colesterol y los triglicéridos
La microalga Coccomyxa onubensis debe su nombre a que fue aislada en Riotinto (Huelva). Es un extremófilo, ya que el medio en el que vive soporta condiciones extremas; comparable a los ácidos del estómago, y producen ácidos grasos beneficiosos para la salud y moléculas antioxidantes.
La aplicación de este microorganismo se ha orientado hacia industria diversa, como la creación de biocombustible o; como en este caso, en la creación de productos farmacológicos o suplementos alimentarios, debido a su capacidad antimicrobiana y antibiótica.
Los animales se alimentaron durante 108 días con una dieta alta en grasas produciendo sobrepeso y un aumento significativo de los niveles de glucosa, triglicéridos y colesterol. Posteriormente se suministró polvo de C. onubensis junto a la dieta alta en grasas con tres grupos diferenciados. El primero de ellos sólo recibió una alimentación rica en grasas, el segundo, dieta similar, pero con estatina y, al tercero, se le proporcionó el mismo tipo de ingesta pero añadiendo la microalga. Los resultados demuestran que los datos de los dos últimos grupos son idénticos.
Dieta equilibrada y ejercicio moderado
Los investigadores parten de la hipótesis de que el tratamiento simultáneo con ambas opciones, junto a una dieta equilibrada y la realización de ejercicio moderado, sería una solución adecuada para controlar la enfermedad cardiovascular.
Los estudios clínicos se realizarán en colaboración con la Unidad de Lípidos y Riesgo vascular del Hospital Infanta Elena. «Si todo va bien, y conseguimos la financiación necesaria, en poco tiempo podría disponerse de un suplemento que ayude a estos pacientes que no logran erradicar su enfermedad; a pesar de seguir las recomendaciones y tratamientos médicos habituales», concluye el investigador.
La ingesta de la microalga ayudará a pacientes con síndrome metabólico, una dolencia que agrupa diabetes, obesidad, hipertensión, hipercolesterolemia y otros problemas de salud. Esta investigación se ha desarrollado mediante la financiación del grupo de investigación ‘Biotecnología de algas’ de la Universidad de Huelva, a través del Plan Andaluz de Investigación, Desarrollo e Innovación.